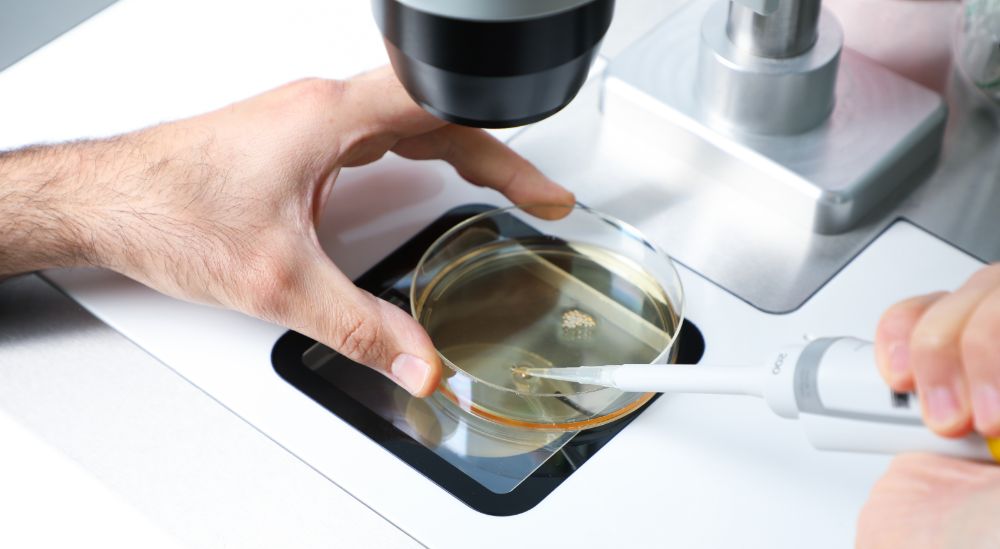
Azoury IVF Lebanon Clinic embryologist performing ICSI Azoury IVF Lebanon Clinic embryologist performing ICSI

Dr. Joseph Azoury has performed more than 40,000 IVF cycles. This number does not only reflect his great experience but it is also a living proof of his high success rate, the trust of his patients and the great reputation that he has worked so hard to build throughout the years.
AI Embryoscope
Azoury IVF Clinic always offers the most up-to-date technology in the IVF field. We are the first and only IVF clinic in Lebanon equipped with the Embryoscope AI technology that allows better embryo selection, more stable embryo culture conditions and full transparency in the IVF lab.
Opening Hours
- 07.30 - 15.30
- 07.30 - 14.30
- 07.30 - 14.30
- 07.30 - 14.30
- 07.30 - 15.30
- 07.30 - 14.30
- Closed
The leading IVF clinic in Lebanon
Located in Lebanon, Azoury IVF Clinic was one of the first IVF centers in the Middle East. In 2024, it remains the leader in this field and offers all types of fertility treatment including egg and sperm donations. The number of procedures we perform yearly is the best indicator of our high success rate and great reputation. All our medical team receive their training from Dr. Joseph Azoury, our clinic’s founder and medical director who is distinguished by his very high experience and humanity.
We know what building a family means for our patients and we always do our best to help them achieve their parenthood dream in God’s will.
To get a free whatsapp consultation or book your appointment today!
Click HereOur Services
Our Doctors
Trust the professionals